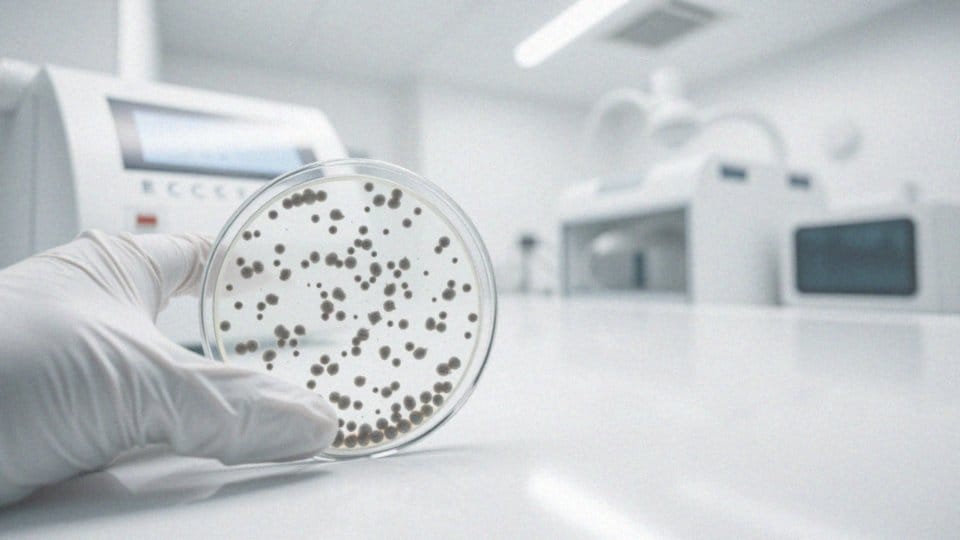

Spis treści
Co to są bardzo liczne bakterie w moczu?
Obecność licznych bakterii w moczu zazwyczaj sygnalizuje zakażenie układu moczowego – infekcję wywołaną przez szkodliwymi mikroorganizmami, które przedostały się do dróg moczowych. Taki stan rzeczy wymaga interwencji, najczęściej z użyciem antybiotyków, a podstawą do postawienia diagnozy jest analiza moczu. Badanie to umożliwia szybkie wykrycie bakterii oraz identyfikację konkretnych szczepów odpowiedzialnych za infekcję. Aby leczenie było skuteczne, powinno opierać się na antybiogramie, który precyzyjnie wskazuje, które antybiotyki będą najbardziej efektywne w zwalczaniu zidentyfikowanych bakterii. Warto dodać, że infekcje układu moczowego częściej dotykają kobiety ze względu na ich anatomię – krótsza cewka moczowa ułatwia bakteriom migrację do pęcherza, zwiększając ryzyko infekcji.
Co to jest bakteriomocz znamienny?
Bakteriomocz znamienny wskazuje na obecność bakterii w moczu w określonej ilości, sygnalizując potencjalne zakażenie układu moczowego (ZUM). O bakteriomoczu mówimy, gdy koncentracja bakterii przekracza próg, zazwyczaj powyżej 10^5 CFU/ml (jednostek tworzących kolonie na mililitr). Wykrycie tak znacznej liczby drobnoustrojów pozwala na rozpoznanie ZUM. Chociaż Escherichia coli jest najczęstszym sprawcą infekcji, inne bakterie również mogą być przyczyną problemu, stąd tak ważna jest szczegółowa analiza moczu.
Co oznacza wysoka liczba bakterii w moczu?
Wysoka liczba bakterii w moczu zazwyczaj sygnalizuje infekcję układu moczowego, stan zapalny wymagający interwencji medycznej. Częstą przyczyną tych infekcji bywają nieprawidłowe nawyki higieniczne, takie jak niedokładne opróżnianie pęcherza, które stwarza idealne warunki do rozwoju bakterii. Escherichia coli jest tu częstym sprawcą, ale sama obecność bakterii to nie jedyny wskaźnik problemu. Równie istotne jest podwyższone stężenie azotynów i leukocytów, które dodatkowo potwierdzają obecność infekcji. W takiej sytuacji konsultacja lekarska jest nieodzowna, a wdrożenie odpowiedniej terapii antybiotykowej – kluczowe. Wybór konkretnego antybiotyku powinien opierać się na wynikach szczegółowych badań laboratoryjnych, aby zapewnić jego skuteczność.
Jakie bakterie najczęściej występują w moczu?
Escherichia coli to główny sprawca infekcji pęcherza, odpowiedzialny za imponującą większość tych dolegliwości, bo szacuje się, że za 75-95% przypadków. U młodych, aktywnych seksualnie kobiet, częstym winowajcą bywa również Staphylococcus saprophyticus. Niemniej jednak, nie tylko te bakterie mogą powodować zakażenia układu moczowego (ZUM). Takie mikroorganizmy jak:
- Proteus mirabilis,
- Klebsiella spp.,
- Enterococcus spp. również mogą być źródłem problemów.
Aby precyzyjnie określić, który konkretnie drobnoustrój wywołał daną infekcję, niezbędne jest wykonanie posiewu moczu. To kluczowe badanie pozwala dobrać antybiotyk idealnie dopasowany do zidentyfikowanego patogenu. Taka celowana terapia jest niezwykle skuteczna, ponieważ działa prosto na wykryty czynnik chorobotwórczy. A jak E. coli trafia do układu moczowego? Zazwyczaj bakterie te migrują tam z przewodu pokarmowego.
Jakie są objawy obecności bakterii w moczu?
Objawy infekcji układu moczowego mogą być zróżnicowane, a ich charakter zależy przede wszystkim od lokalizacji zakażenia. Do najczęstszych symptomów należą:
- częste, naglące potrzeby oddania moczu,
- silne parcie na pęcherz,
- pieczenie i ból podczas mikcji,
- zmiana barwy lub przejrzystości moczu,
- mętny lub krwisty mocz.
Kiedy infekcja obejmuje nerki, może pojawić się tępy ból w lędźwiach, czyli w dolnej części pleców. Często towarzyszą mu gorączka, dreszcze, a nawet nudności i wymioty. Z drugiej strony, u wielu osób zakażenie przebiega zupełnie bezobjawowo, co określamy mianem bakteriomoczu bezobjawowego. W takim przypadku jedynym sygnałem ostrzegawczym jest obecność bakterii w moczu, ujawniona podczas rutynowego badania. Właśnie dlatego tak istotne jest regularne wykonywanie badań diagnostycznych.
Jak rozpoznać zakażenie układu moczowego?

Aby rozpoznać zakażenie układu moczowego (ZUM), kluczowe są dwa badania:
- ogólna analiza moczu,
- posiew.
Pierwsze z nich pozwala wykryć obecność leukocytów, inaczej białych krwinek, a także azotynów i bakterii, co stanowi wstępny sygnał o potencjalnej infekcji. Jednak to posiew moczu ma decydujące znaczenie, ponieważ precyzyjnie identyfikuje bakterię odpowiedzialną za zakażenie i ustala jej wrażliwość na konkretne antybiotyki. Wynik tego badania, czyli antybiogram, jest niezwykle pomocny w doborze odpowiedniego leczenia. Oprócz analiz laboratoryjnych, lekarz zwraca uwagę na symptomy zgłaszane przez pacjenta. Częste oddawanie moczu oraz ból i pieczenie podczas mikcji mogą sugerować ZUM. Dlatego też, diagnoza opiera się na bakteriomoczu znamiennym, potwierdzonym badaniami, oraz na subiektywnych dolegliwościach pacjenta.
Jakie są przyczyny bakteriomoczu?

Najczęstszą przyczyną bakteriomoczu, czyli obecności bakterii w moczu, są infekcje wstępujące. W tego typu przypadkach, drobnoustroje, zazwyczaj pochodzące z przewodu pokarmowego – jak choćby *E. coli* – przedostają się do układu moczowego przez cewkę moczową. Co zwiększa prawdopodobieństwo wystąpienia bakteriomoczu? Niewątpliwie zbyt rzadkie wizyty w toalecie oraz niedostateczna higiena intymna odgrywają tu rolę. Dodatkowo, istotnymi elementami sprzyjającymi rozwojowi infekcji są:
- obecność cewnika,
- kamica nerkowa,
- ewentualne wrodzone nieprawidłowości w budowie dróg moczowych.
Warto również wiedzieć, że ryzyko bakteriomoczu rośnie po przeprowadzeniu inwazyjnych badań diagnostycznych w obrębie układu moczowego. Zastój moczu stwarza idealne warunki dla rozmnażania się bakterii. Trzeba jednak wyraźnie rozróżnić bakteriomocz od zakażenia układu moczowego (ZUM), które jest stanem zapalnym wywołanym przez te bakterie. Kobiety są bardziej podatne na ZUM ze względu na krótszą cewkę moczową, co niestety ułatwia bakteriom dotarcie do pęcherza.
Jakie są czynniki ryzyka dla kobiet w ciąży?
Ciąża wiąże się ze zwiększonym ryzykiem bakteriomoczu i zakażeń układu moczowego (ZUM) u kobiet. Jest to spowodowane zmianami fizjologicznymi zachodzącymi w ciele przyszłej mamy.
Jakie czynniki zwiększają to ryzyko?
- zmiany hormonalne – wysoki poziom progesteronu powoduje rozluźnienie mięśni gładkich, w tym moczowodów, co spowalnia przepływ moczu i sprzyja jego zaleganiu,
- ucisk rosnącej macicy na pęcherz moczowy i moczowody, co utrudnia ich opróżnianie,
- osłabienie odporności organizmu kobiety, zwiększając podatność na infekcje, w tym ZUM,
- częste występowanie cukru w moczu u ciężarnych stwarza idealne warunki dla rozwoju bakterii,
- kobiety, które w przeszłości doświadczyły ZUM, są bardziej narażone na ich nawrót w czasie ciąży.
Szybkie wykrycie i leczenie bakteriomoczu u przyszłych mam jest niezwykle ważne, ponieważ pomaga zapobiec poważnym komplikacjom zarówno dla niej, jak i dla dziecka.
Czym jest bezobjawowy bakteriomocz? Mówimy o nim, gdy w moczu obecne są bakterie (≥10^5 CFU/ml), ale nie występują typowe symptomy ZUM, takie jak ból, pieczenie, częste oddawanie moczu czy uczucie parcia na pęcherz. Pomimo braku odczuwalnych objawów, ten stan nie jest obojętny, szczególnie w ciąży. Nieleczony może prowadzić do poważnych problemów, takich jak odmiedniczkowe zapalenie nerek, przedwczesny poród czy niska masa urodzeniowa dziecka. Właśnie dlatego badanie w kierunku bakteriomoczu bezobjawowego jest standardową procedurą u kobiet spodziewających się dziecka.
W przypadku podejrzenia bakteriomoczu, wykonuje się szereg badań. Mają one na celu potwierdzenie obecności bakterii, identyfikację ich rodzaju i określenie wrażliwości na antybiotyki. Do podstawowych badań zalicza się:
- badanie ogólne moczu, które ocenia jego wygląd, pH, ciężar właściwy oraz obecność różnych substancji, takich jak białko, glukoza, ketony, leukocyty, erytrocyty i azotyny (obecność leukocytów i azotynów może sugerować infekcję),
- posiew moczu z antybiogramem – to badanie mikrobiologiczne pozwala zidentyfikować gatunki bakterii i określić ich liczbę; antybiogram z kolei dostarcza informacji o wrażliwości bakterii na różne antybiotyki, co pomaga w doborze odpowiedniego leczenia,
- badanie osadu moczu, które pozwala na ocenę elementów morfotycznych w moczu, takich jak erytrocyty, leukocyty, wałeczki i kryształy.
W niektórych przypadkach lekarz może zlecić dodatkowe badania, np. USG układu moczowego, aby wykluczyć inne potencjalne przyczyny.
Badanie moczu odgrywa zasadniczą rolę w diagnozowaniu bakteriomoczu:
- pozwala na wykrycie bakterii (badanie ogólne może na to wskazywać, a posiew potwierdza i określa nasilenie),
- określenie gatunku bakterii (co jest niezbędne do wyboru właściwego leczenia),
- ocenę stanu zapalnego (obecność leukocytów i azotynów to wskaźniki zapalenia),
- dobór leczenia (antybiogram wskazuje wrażliwość bakterii na antybiotyki),
- monitorowanie skuteczności terapii (powtórne badanie ocenia ustąpienie infekcji).
Wczesne wykonanie badania moczu jest niezwykle ważne, ponieważ umożliwia szybką diagnozę bakteriomoczu i zapobiega potencjalnym powikłaniom.
Leczenie ZUM, w tym bakteriomoczu, jest uzależnione od rodzaju i nasilenia infekcji, a także ogólnego stanu zdrowia pacjenta. Podstawą terapii są antybiotyki, dobierane indywidualnie na podstawie wyników antybiogramu. W przypadku niepowikłanych ZUM, takich jak zapalenie pęcherza, zazwyczaj wystarcza krótkotrwała terapia (3-7 dni). Bardzo ważne jest, aby stosować się do zaleceń lekarza i nie przerywać kuracji, nawet jeśli objawy ustąpią. Dodatkowo, zaleca się:
- spożywanie dużej ilości płynów, co pomaga wypłukać bakterie z dróg moczowych,
- unikanie substancji drażniących pęcherz (alkohol, kofeina, ostre przyprawy),
- stosowanie leków przeciwbólowych dostępnych bez recepty,
- spożywanie żurawiny, która utrudnia bakteriom przyleganie do ścianek dróg moczowych.
Powikłane ZUM mogą wymagać hospitalizacji i dożylnego podawania antybiotyków. W przypadku kobiet w ciąży leczenie ZUM jest bezwzględnie konieczne, jednak należy unikać antybiotyków, które mogą być szkodliwe dla płodu. Lekarz prowadzący ciążę dobiera odpowiedni antybiotyk i ustala czas trwania leczenia. Po zakończeniu terapii, lekarz zazwyczaj zleca wykonanie badania kontrolnego.
Obecność dużej ilości bakterii w moczu, czyli bakteriomocz, może prowadzić do różnorodnych skutków, które zależą od:
- obecności stanu zapalnego (bakteriomocz nie zawsze oznacza ZUM; bez stanu zapalnego mówimy o bakteriomoczu bezobjawowym),
- rodzaju bakterii (niektóre są bardziej zjadliwe),
- stanu zdrowia pacjenta (osoby z obniżoną odpornością są bardziej narażone),
- szybkości wdrożonego leczenia (im wcześniej, tym mniejsze ryzyko powikłań).
Do najczęstszych skutków należą ZUM (ból i pieczenie podczas oddawania moczu, częstomocz, ból w podbrzuszu; w przypadku infekcji nerek – ból w lędźwiach i gorączka), odmiedniczkowe zapalenie nerek (poważne zakażenie nerek), przedwczesny poród (bakteriomocz u ciężarnych zwiększa to ryzyko), zapalenie prostaty (u mężczyzn) oraz powikłania pooperacyjne (zwiększone ryzyko infekcji po operacjach w obrębie układu moczowego). Nieleczony bakteriomocz może skutkować poważnymi konsekwencjami zdrowotnymi:
- przewlekłe zapalenie pęcherza (nawracające infekcje prowadzą do chronicznego stanu zapalnego),
- uszkodzenie nerek (następstwo nieleczonego odmiedniczkowego zapalenia nerek),
- nadciśnienie tętnicze (spowodowane uszkodzeniem nerek),
- zwiększone ryzyko w ciąży (m.in. przedwczesny poród),
- zwężenie cewki moczowej (efekt przewlekłych stanów zapalnych),
- zespół pęcherza nadreaktywnego (wynik zapaleń pęcherza),
- sepsa (w skrajnych przypadkach, zakażenie prowadzi do sepsy, stanu zagrażającego życiu).
Właśnie dlatego tak ważne jest wczesne wykrycie i podjęcie odpowiedniego leczenia.
Co to jest bezobjawowy bakteriomocz?
Bezobjawowy bakteriomocz to sytuacja, w której w moczu wykrywa się znaczną ilość bakterii – co najmniej 100 000 CFU/ml. Charakterystyczne jest, że nie występują przy tym żadne dolegliwości typowe dla infekcji układu moczowego, takie jak ból, pieczenie podczas mikcji czy nagłe parcie na pęcherz. Chociaż obecność bakterii w moczu może być niepokojąca, w większości przypadków nie wymaga interwencji antybiotykowej. Istnieją jednak wyjątki od tej reguły.
U kobiet ciężarnych bezobjawowy bakteriomocz stanowi poważne zagrożenie, zwiększając prawdopodobieństwo rozwoju ostrego zapalenia pęcherza, a nawet odmiedniczkowego zapalenia nerek. Co więcej, wiąże się z ryzykiem przedwczesnego porodu lub niskiej wagi urodzeniowej dziecka. Dlatego w ich przypadku konieczne jest wdrożenie profilaktycznego leczenia. Leczenie jest również rekomendowane osobom, które przygotowują się do zabiegów urologicznych. Ma to na celu minimalizację ryzyka pooperacyjnych infekcji. U dzieci natomiast, bezobjawowy bakteriomocz rzadko prowadzi do komplikacji. Szczególną grupą ryzyka są pacjenci z cewnikiem, u których stwierdzenie bakterii w moczu jest stosunkowo częste.
Jakie badania są wykonywane w przypadku bakteriomoczu?
W procesie diagnozowania bakteriomoczu, czyli obecności bakterii w drogach moczowych, kluczowe znaczenie mają badania laboratoryjne. Na początku wykonuje się badanie ogólne moczu, które pozwala wstępnie ocenić, czy w moczu znajdują się bakterie oraz leukocyty, których obecność sygnalizuje stan zapalny. Następnie, niezwykle istotny jest posiew moczu wraz z antybiogramem. Ten rodzaj badania pozwala na:
- identyfikację konkretnego szczepu bakterii odpowiedzialnego za infekcję,
- określenie jego wrażliwości na różne antybiotyki.
Informacja ta jest niezmiernie ważna, ponieważ od niej zależy dobór efektywnej terapii. Aby jednak uzyskać pełniejszy obraz stanu układu moczowego, lekarz może zalecić wykonanie dodatkowych badań obrazowych, takich jak USG nerek i pęcherza moczowego, które dostarczają cennych danych. Ponadto, badania krwi, w tym morfologia i CRP, pozwalają ocenić ogólny stan pacjenta oraz stopień zaawansowania stanu zapalnego. Wszystkie te badania łącznie uzupełniają obraz kliniczny i pomagają w postawieniu trafnej diagnozy.
Jakie znaczenie ma badanie moczu w diagnozowaniu bakteriomoczu?
Badanie moczu to fundamentalne narzędzie diagnostyczne w przypadku bakteriomoczu. Pozwala ono na:
- identyfikację rodzaju bakterii obecnych w układzie moczowym,
- określenie rodzaju bakterii obecnych w układzie moczowym poprzez badanie ogólne,
- określenie rodzaju bakterii obecnych w układzie moczowym poprzez posiew moczu.
Oprócz wykrywania samych mikroorganizmów, analiza próbki moczu dostarcza informacji o nasileniu stanu zapalnego, o czym świadczy obecność leukocytów oraz azotynów. Niezwykle istotne jest również wykonanie antybiogramu, który stanowi integralną część posiewu. Umożliwia on bowiem precyzyjne dobranie antybiotyku, który będzie skuteczny w zwalczaniu konkretnego rodzaju bakterii. Antybiogram wskazuje, które leki wykazują aktywność wobec danego patogenu. Co więcej, regularne badania moczu pozwalają monitorować postępy leczenia i upewnić się, że infekcja została całkowicie wyleczona po zastosowaniu farmakoterapii.
Jak powinno wyglądać leczenie zakażeń układu moczowego?
W walce z infekcjami układu moczowego (ZUM) kluczową rolę odgrywają antybiotyki. Lekarz identyfikuje bakterię odpowiedzialną za infekcję, a następnie dobiera antybiotyk, na który ta bakteria jest najbardziej wrażliwa. Wybór odpowiedniego leku dyktuje antybiogram, który wskazuje, które antybiotyki są skuteczne w zwalczaniu konkretnego szczepu bakterii.
Oprócz terapii antybiotykowej, istotne jest również wsparcie organizmu w walce z infekcją. Co możemy zrobić?
- zwiększmy spożycie płynów – pijąc więcej, przepłukujemy drogi moczowe, pomagając w usunięciu bakterii,
- w łagodzeniu nieprzyjemnych objawów, takich jak ból i skurcze, pomocne mogą okazać się leki przeciwbólowe i rozkurczowe.
Nawracające infekcje układu moczowego wymagają bardziej szczegółowego dochodzenia. W takich przypadkach konieczne jest przeprowadzenie dodatkowych badań, które pomogą ustalić przyczynę problemu. Może nią być:
- wada w budowie dróg moczowych,
- obecność kamieni nerkowych,
- zaburzenia metaboliczne.
Pamiętajmy! Kuracji antybiotykowej nie wolno przerywać przedwcześnie, nawet jeśli poczujemy się lepiej. Niedokończona terapia może skutkować nawrotem infekcji, a co gorsza, prowadzić do rozwoju lekooporności bakterii, co w przyszłości utrudni skuteczne leczenie.
Jakie są skutki licznych bakterii w moczu?
Obecność bakterii w moczu może prowadzić do rozmaitych konsekwencji, których skala zależy od szybkości interwencji medycznej i kondycji organizmu. Ignorowanie infekcji grozi poważnymi komplikacjami zdrowotnymi. Może dojść do bolesnego zapalenia pęcherza moczowego, a w skrajnych przypadkach nawet do odmiedniczkowego zapalenia nerek, które jest poważnym zagrożeniem. W najgorszym scenariuszu może rozwinąć się sepsa, zagrażająca życiu. Szczególnej uwagi wymaga sytuacja kobiet spodziewających się dziecka, gdyż infekcja dróg moczowych zwiększa prawdopodobieństwo przedwczesnego rozwiązania i niesie ze sobą potencjalne komplikacje dla noworodka. Wykrycie w mililitrze moczu ponad 100 000 bakterii, zwłaszcza Escherichia coli (E. coli), stanowi poważny sygnał ostrzegawczy, sugerujący ryzyko rozprzestrzenienia się infekcji na górne partie układu moczowego. Dlatego tak ważne jest, aby jak najszybciej wykryć problem i niezwłocznie podjąć leczenie. Pozwoli to uniknąć długotrwałych i poważnych konsekwencji zdrowotnych. Nie odkładaj wizyty u specjalisty – zdrowie jest najważniejsze!
Jakie są długoterminowe konsekwencje nieleczonego bakteriomoczu?
Nieleczony bakteriomocz może prowadzić do poważnych, długotrwałych konsekwencji zdrowotnych. Przede wszystkim, istnieje poważne ryzyko:
- rozwoju przewlekłego zapalenia nerek, co z kolei może skutkować trwałym uszkodzeniem tych kluczowych organów, a w skrajnych przypadkach nawet ich niewydolnością,
- wystąpienia nadciśnienia tętniczego,
- powikłań ciążowych (u przyszłych mam brak interwencji medycznej w przypadku bakteriomoczu niesie ze sobą ryzyko przedwczesnego porodu oraz niskiej wagi urodzeniowej noworodka),
- sepsy, stanowiącej ostrą i potencjalnie śmiertelną reakcję organizmu na infekcję.
Dodatkowo, niektóre szczepy bakterii potrafią tworzyć biofilm, który chroni je przed działaniem antybiotyków, znacząco utrudniając proces leczenia. Dlatego tak ważne jest szybkie zdiagnozowanie bakteriomoczu i podjęcie odpowiednich działań terapeutycznych, aby skutecznie zapobiec wystąpieniu tych poważnych komplikacji.